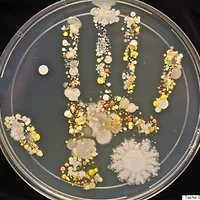

우리나라는 국민연금이 2060년에 고갈된다고 심각한 문제라며
GDP의 140%를 확충해야 된다고
문형표 보건복지부 장관이 연금보험료를 두배 올려야 된다고 주장했죠
우리나라 연금보유액의 현수준은 GDP의 35%... 이것만으로도 세계 1위
높다고 하는 일본이 가장 많이 보유했을 때도 GDP의 30% 정도라고 하네요.
우리나라는 2060년 고갈이 심각한 문제라고 하는데
일본은 5년치의 적립금만 보유한다고 하고
독일은 연금을 7일치만 적립해 둔다고 하네요
국민연금.. 뭐 물론 제 부모님 세대는 혜택을 받고 계시지만
지금의 우리에겐 그저 또하나의 세금이라고 밖에 생각되지 않는...
그리고 더 우울한건 그 돈들이 어떻게 쓰이고 있는지,
어디에 투자되고 있는지 명확하지 않다는 사실...
외국 투자기업들에게 까지 큰손으로 대접받는 국민연금의 실체
어떤지 궁금하지 않으신가요?
그냥 한번 읽어보시라고 기사 링크합니다~
http://www.pressian.com/news/article.html?no=126498&ref=nav_mynews